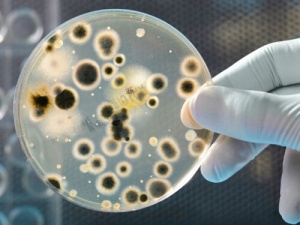
Olika typer av bakterier som finns på pengar

Olika typer av bakterier som finns på pengar
I den här artikeln kommer vi att diskutera olika typer av bakterier som finns på pengar, på både mynt och sedlar. Du kommer att bli överraskad!
Bakterier på pengar
Kreditkort och bankkort används mer och mer nuförtiden, men vi kommer ändå i kontakt med sedlar och mynt varje dag. Vi rör vid pengar som är fulla av bakterier varje dag. Det kan skada vår hälsa om vi inte vidtar lämpliga hygienåtgärder för att undvika dessa bakterier som finns på pengar.
Det självklara tipset är att tvätta händerna. Man kan undvika många hälsoproblem, genom något så enkelt. När du rör vid en sedel så får du bakterier på händerna som sedan kan komma in i kroppen om du rör vid munnen eller ögonen.
Enligt studier gjorda i USA och Colombia har sedlar stora mängder bakterier vilka kan orsaka infektioner, samt mikroorganismer som kan ge allvarliga sjukdomar som vårt immunförsvar kanske inte klarar av att bekämpa. Enligt studierna kan man även finna upp till sju sorters bakterier på mynt.
Staphylococcus Epidermidis
Den här bakterien orsakar infektioner i olika delar av kroppen; några symtom kan vara: feber, trötthet, plötslig smärta, snabb andning och puls, samt överdriven svettning med mera.
Baciller
Vissa baciller ger inga symtom, emedan andra kan bilda patogener i både människor och djur. Vissa bakteriestammar kan orsaka kräkningar och diarré inom fem till tio timmar efter att de har kommit i kontakt med en värd.
Streptokocker
Streptokocker orsakar en mängd allvarliga sjukdomar som meningit (hjärnhinneinflammation), bakteriell lunginflammation och faryngit, bland andra. Men det finns vissa typer av den här bakterien som inte är patogena.
E. coli
Du kan få magont, diarré (ofta med blod i), kräkningar, illamående och feber av denna mycket smittsamma bakterie. Symtomen uppstår tre till fyra dagar efter att du har blivit infekterad.
Glöm inte att tvätta händerna!!
Många av de här bakterierna finns i vår omgivning, så det är lätt att smittas av dem. Dessa mikroorganismer kommer lätt i kontakt med våra kroppar, och de kan orsaka sjukdomar om vi inte förebygger det genom att tvätta händerna innan vi äter. Kom ihåg att fastän vissa bakterier bara orsakar enkla sjukdomar, så kan andra leda till värre saker som gastroenterit, eller till och med döden.
Det är omöjligt att undvika att röra vid pengar och bakterier, men vi bör vara försiktiga och tvätta händerna efter att vi har hanterat pengar, innan vi äter, rör vid andra delar av kroppen eller håller i spädbarn. Dessa enkla åtgärder kan förebygga hälsoproblem.
Kom ihåg…
Mynt kan ha över 2400 bakterier på sig, varav vissa liknar de som finns på sedlar; men mikroorganismer som sitter på sedlar växer i takt med att de förflyttas från hand till hand. En sjuk persons mikrober skickas vidare till alla som rör den besmittade sedeln.
Glöm inte bort att bakterier främst sprids mellan människor via mynt och sedlar, vart du än är i världen; därför är det bra att inte låta barn hantera sedlar eller mynt. Undvik att röra vid din mun, ögon eller andra delar av kroppen efter att du har rört vid pengar. Se också till att du håller dina händer rena hela tiden!
I den här artikeln kommer vi att diskutera olika typer av bakterier som finns på pengar, på både mynt och sedlar. Du kommer att bli överraskad!
Bakterier på pengar
Kreditkort och bankkort används mer och mer nuförtiden, men vi kommer ändå i kontakt med sedlar och mynt varje dag. Vi rör vid pengar som är fulla av bakterier varje dag. Det kan skada vår hälsa om vi inte vidtar lämpliga hygienåtgärder för att undvika dessa bakterier som finns på pengar.
Det självklara tipset är att tvätta händerna. Man kan undvika många hälsoproblem, genom något så enkelt. När du rör vid en sedel så får du bakterier på händerna som sedan kan komma in i kroppen om du rör vid munnen eller ögonen.
Enligt studier gjorda i USA och Colombia har sedlar stora mängder bakterier vilka kan orsaka infektioner, samt mikroorganismer som kan ge allvarliga sjukdomar som vårt immunförsvar kanske inte klarar av att bekämpa. Enligt studierna kan man även finna upp till sju sorters bakterier på mynt.
Staphylococcus Epidermidis
Den här bakterien orsakar infektioner i olika delar av kroppen; några symtom kan vara: feber, trötthet, plötslig smärta, snabb andning och puls, samt överdriven svettning med mera.
Baciller
Vissa baciller ger inga symtom, emedan andra kan bilda patogener i både människor och djur. Vissa bakteriestammar kan orsaka kräkningar och diarré inom fem till tio timmar efter att de har kommit i kontakt med en värd.
Streptokocker
Streptokocker orsakar en mängd allvarliga sjukdomar som meningit (hjärnhinneinflammation), bakteriell lunginflammation och faryngit, bland andra. Men det finns vissa typer av den här bakterien som inte är patogena.
E. coli
Du kan få magont, diarré (ofta med blod i), kräkningar, illamående och feber av denna mycket smittsamma bakterie. Symtomen uppstår tre till fyra dagar efter att du har blivit infekterad.
Glöm inte att tvätta händerna!!
Många av de här bakterierna finns i vår omgivning, så det är lätt att smittas av dem. Dessa mikroorganismer kommer lätt i kontakt med våra kroppar, och de kan orsaka sjukdomar om vi inte förebygger det genom att tvätta händerna innan vi äter. Kom ihåg att fastän vissa bakterier bara orsakar enkla sjukdomar, så kan andra leda till värre saker som gastroenterit, eller till och med döden.
Det är omöjligt att undvika att röra vid pengar och bakterier, men vi bör vara försiktiga och tvätta händerna efter att vi har hanterat pengar, innan vi äter, rör vid andra delar av kroppen eller håller i spädbarn. Dessa enkla åtgärder kan förebygga hälsoproblem.
Kom ihåg…
Mynt kan ha över 2400 bakterier på sig, varav vissa liknar de som finns på sedlar; men mikroorganismer som sitter på sedlar växer i takt med att de förflyttas från hand till hand. En sjuk persons mikrober skickas vidare till alla som rör den besmittade sedeln.
Glöm inte bort att bakterier främst sprids mellan människor via mynt och sedlar, vart du än är i världen; därför är det bra att inte låta barn hantera sedlar eller mynt. Undvik att röra vid din mun, ögon eller andra delar av kroppen efter att du har rört vid pengar. Se också till att du håller dina händer rena hela tiden!
Samtliga citerade källor har granskats noggrant av vårt team för att säkerställa deras kvalitet, tillförlitlighet, aktualitet och giltighet. Bibliografin för denna artikel ansågs vara tillförlitlig och av akademisk eller vetenskaplig noggrannhet.
- Cecchini, E. (2001). Infectología y enfermedades infecciosas. Madrid: Journal.
- Kumate, J. (1998). Manual de Infectología. Chichuahua: Méndez.
- Wilson, W. R. et al. (2001). Diagnóstico y tratamiento de enfermedades infecciosas. México, DF: Manual Moderno.
- Gedik, H., Voss, T., Voss, A. (2013). Money and transmission of bacteria. Antimicrobial Resistance & Infection Control. 2(1). DOI:10.1186/2047-2994-2-22
- Kuria, J., Wahome, R., Jobalamin, M., Kariuki, s. (2009). Profile Of Bacteria And Fungi On Money Coins. East African medical journal. 86(4):151-5. DOI:10.4314/eamj.v86i4.46943.
- Vriesekoop F., Chen J., Oldaker J., et al. (2016). Dirty Money: A Matter of Bacterial Survival, Adherence, and Toxicity. Microorganisms. 4(4): 42. doi: 10.3390/microorganisms4040042. PMID: 27886085; PMCID: PMC5192525.
- Otto, M. (2009). Staphylococcus epidermidis — the ‘accidental’ pathogen. Nat Rev Microbiol 7, 555–567. https://doi.org/10.1038/nrmicro2182
Denna text erbjuds endast i informativt syfte och ersätter inte konsultation med en professionell. Vid tveksamheter, rådfråga din specialist.









